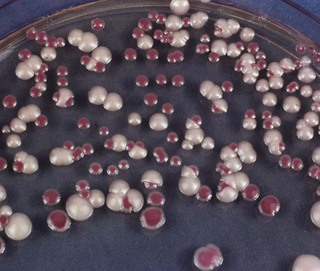
image

Chapter 22 Fungi of relevance to dentistry
The study of fungi is called mycology. Fungi are eukaryotic microorganisms, as opposed to bacteria together with Archaea that are prokaryotic (Chapter 2). By far the most important fungus of relevance in dentistry is a yeast belonging to the genus Candida. It is an oral commensal in about half of the general population. In this chapter, the general characteristics of some medically important fungi will be given, but the emphasis will be on fungal infections of the oral cavity – the oral mycoses, especially those caused by the Candida species.
Morphology
Fungi exhibit two basic structural forms: the yeast form (Fig. 22.1) and the mould form. While some fungi are capable of existing as both forms (dimorphic) at different times, others exist in one form only. This morphological switching depends on factors such as the environment and nutrient supply. Generally, dimorphic fungi exist as moulds in the natural environment (and in laboratory culture) and as yeasts in tissue:
Reproduction
Both asexual and sexual modes of reproduction are seen in fungi. It is believed that the sexual forms of fungi are not found in clinical material.
Classification
Taxonomy of fungi is a complex subject not dealt with here. Most of the medically important fungi are classified as fungi imperfecti as their sexual forms have not been identified. Fungi of medical importance are classified into:
Cultural requirements
Medically important fungi require different cultural and growth conditions in comparison to bacteria:
These mycological media differ from conventional bacteriological media in having a high carbohydrate content (SAB usually contains 3% dextrose or sucrose) and an acidic pH (approximately 4.0). Both these conditions are inhibitory to most bacteria. The SAB medium may also be supplemented with antibiotics to suppress bacterial growth.
Pathogenicity
In general, medically important fungi do not possess the virulent attributes of bacteria such as exotoxins and endotoxins (an exception is the exotoxin, aflatoxin, produced by Aspergillus species); hence, they cause slowly progressive chronic infections rather than the acute disease commonly seen in bacterial or viral diseases. However, they may cause life-threatening acute infections in immunocompromised patients (e.g. those with acquired immune deficiency syndrome (AIDS)). The oral fungal pathogen Candida possesses a number of virulent attributes, including:
Human mycoses
Human infections caused by fungi can be divided into:
Superficial mycoses
Superficial mycoses involve the mucosal surfaces and keratin-containing structures of the body (skin, nails and hair). These infections, relatively common in western countries, are in general cosmetic problems and are not life-threatening. Superficial mycoses include:
Subcutaneous mycoses
Subcutaneous mycoses involve the subcutaneous tissue and rarely disseminate. They are the result of traumatic implantation of environmental fungi leading to chronic progressive disease, tissue destruction and sinus formation. Examples include sporotrichosis and mycetoma (Madura foot), which are common in the tropics and rare in the West.
Systemic mycoses (deep mycoses)
By far the most serious, and often fatal, systemic mycoses involve the internal organ systems of the body. The organisms are generally acquired through the respiratory tract and spread haematogenously. In the developed world, they are increasingly seen in compromised patients with impaired defence systems when the organisms behave as opportunistic pathogens. In the developing world, systemic mycoses (e.g. histoplasmosis, blastomycosis and coccidioidomycosis) occur in otherwise healthy individuals.
Opportunistic fungal infections
When fungi (such as Candida albicans) that are generally innocuous for healthy humans cause disease in compromised patient groups, they are called opportunistic pathogens. Such opportunistic mycoses are increasingly common owing to a global rise in compromised individuals such as human immunodeficiency virus (HIV)-infected patients, organ transplant recipients on immunosuppressive therapy and cancer patients on cytotoxic and radiation therapy.
Yeasts
Yeasts are unicellular, oval or spherical organisms, 2–5 µm in diameter, and stain positively by the Gram method (Fig. 22.2). They are commonly seen to have lateral projections or buds called daughter cells. These gradually enlarge in size until they split off from the parent or mother cell to produce the next generation. Most yeasts develop pseudohyphae (chains of elongated budding cells devoid of septa or cross walls) but only a few form true hyphae (septate hyphae). Yeasts of the genus Candida, the most important fungal pathogen in the oral cavity, also form pseudohyphae. It is a common yeast that lives in the oral cavity of about half of the population and is also a resident commensal of the gut. It can cause either superficial or systemic candidiasis (synonym: candidosis). The superficial disease affects:

Fig. 22.2 A Gram-stained film of a smear from the fitting surface of the denture of a patient with Candida-associated denture stomatitis showing the blastospore and hyphal forms of the organism.
The infection is usually endogenous in origin. Several species in the genus Candida are found in humans, including C. albicans, C. glabrata, C. krusei and C. tropicalis (Fig. 22.3), but C. albicans is responsible for the vast majority of infections (>90%). Candida dubliniensis is a newly recognized species of Candida very similar to C. albicans. First isolated from the oral cavity of HIV-infected patients, C. dubliniensis is now known to be a relatively common oral inhabitant in both health and disease.
Fig. 22.3 Candida albicans and Candida tropicalis growing side by side on a special medium (Pagano–Levin agar), which elicits differential colour reactions. Mixed oral candidal infections are not uncommon.
Candida albicans
Habitat and transmission
C. albicans is indigenous to the oral cavity, gastrointestinal tract, female genital tract and sometimes the skin; hence, infection is usually endogenous, although cross infection may occur, e.g. from mother to baby, and among infant siblings.
Characteristics
C. albicans typically grows as spherical to oval budding yeast cells 3–5 × 5–10 µm in size. These yeast-phase cells are also called blastospores (Fig. 22.4), but should not be confused with bacterial spores. Pseudohyphae (elongated filamentous cells joined end to end) are seen, especially at lower incubation temperatures and on nutritionally poor media.
Culture and identification
Cultures grow on Sabouraud medium as creamy-white colonies, flat or hemispherical in shape with a beer-like aroma. C. albicans and C. dubliniensis may be differentiated from other Candida species by their ability to produce germ tubes and chlamydospores:
However, definitive identification of the species is made on the basis of carbohydrate assimilation (aerobic metabolism) and fermentation (anaerobic metabolism) reactions and other biochemical tests; polymerase chain reaction (PCR) diagnostics should soon replace these methodologies in diagnostic laboratories, especially due to their rapidity.
Pathogenicity
Candida species rarely cause disease in the absence of predisposing factors, a vast number of which have been identified, both for superficial and systemic candidiasis (Table 22.1).
Table 22.1 Factors predisposing to oral candidiasis
Superficial candidiasis
Mucocutaneous candidiasis
Mucocutaneous candidiasis involves both the skin and the oral and/or vaginal mucosae. This rare disease is due to heritable or acquired defects in the host immune system or metabolism. Chronic mucocutaneous candidiasis is a rare condition associated with T cell deficiency (see Chapter 35).
Systemic or deep candidiasis
This may involve the lower respiratory tract and urinary tract, with resultant candidaemia (Candida in blood); localization in endocardium, meninges, bone, kidney and eye is common. Untreated disseminated disease is fatal. Susceptible settings include organ transplantation, heart surgery, prosthetic implantation and long-term steroid or immunosuppressive therapy. Rarely, a superficial infection is the cause of disseminated disease.
Diagnosis
Treatment
Candida infections can be treated by three groups of agents: the polyenes, the azoles and the DNA analogues (see Chapter 7). The agents used depend upon the type and severity of infection. Superficial infections can be treated topically with a polyene (nystatin or amphotericin) or an imidazole (miconazole, clotrimazole). Polyenes are also very effective for oral candidal infections. Systemic infections and disseminated candidiasis require intravenous amphotericin, either alone or in combination with flucytosine. The triazole agent fluconazole, effective for both superficial and systemic mycoses, is the drug of choice in treating Candida infections in HIV disease. (However, C. krusei is resistant to fluconazole). The use of newer agents such as echinocandins and terbinafine in dentistry are as yet ill defined.
Cryptococcus
Cryptococcus neoformans is a pathogenic yeast belonging to the Cryptococcus genus. It causes cryptococcosis, especially cryptococcal meningitis.
Habitat and transmission
This yeast is a ubiquitous saprophyte commonly isolated from soil enriched by pigeon droppings. Infection is initiated by inhalation of airborne yeast cells.
Culture and identification
Identification is by sputum and spinal fluid culture on Sabouraud agar. Latex agglutination is used to detect the polysaccharide antigen in urine, blood or spinal fluid. Indian ink preparations of spinal fluid are used in the demonstration of the encapsulated yeast (Fig. 22.5).
Pathogenicity
The thick polysaccharide capsule of the yeast is highly resistant to host immune defences. Life-threatening infections caused by C. neoformans have been steadily increasing over the past few decades due to the onset of AIDS, and the expanded use of immunosuppressive drugs. Cryptococci cause an influenza-like syndrome or pneumonia. Subsequent fungaemia causes infection of the meninges. Reduced cell-mediated immunity exacerbates the infection; immunocompetent people may occasionally develop cryptococcal meningitis. Rarely cryptococcal oral ulceration can be seen in compromised patients such as those with HIV infection.
Filamentous and dimorphic fungi and oral disease
The foregoing text describes one major group of fungi – yeasts – which are of dental and medical relevance. The other two main groups, filamentous and dimorphic fungi, usually do not cause oral disease except in immunocompromised groups. Organisms that are noteworthy and cause oral ulceration are Penicillium marneffei, Blastomyces dermatitidis, Coccidioides immitis, Histoplasma capsulatum and Histoplasma duboisii (Table 22.2).
Table 22.2 Dimorphic fungi that may cause oral ulceration, especially in immunocompromised patients
| Fungus | Disease | Geographic distribution |
|---|---|---|
| Penicillium marneffei | Penicilliosis | South-East Asia |
| Blastomyces dermatitidis | North American blastomycosis | North America, especially Mississippi and Ohio valleys |
| Coccidioides immitis | Coccidioidomycosis | USA from California to Texas; South and Central America |
| Histoplasma capsulatum | Histoplasmosis | Eastern and central USA; occasionally other parts of the world |
| Histoplasma duboisii | African histoplasmosis | Equatorial Africa |
Pathogenicity
In all these cases, infection is usually acquired by inhalation, and the primary lesions are seen in the lungs. In a majority, the initial lesion heals, often asymptomatically, and delayed hypersensitivity develops, with a positive skin test reaction to the appropriate antigen. Progressive disease may affect the lungs, causing cavitation, and/or disseminate widely to involve the skin, oral and other mucous membranes and internal organs. Ulceration is the most common presentation in the oral mucosa.
Diagnosis
Diagnosis may be by direct demonstration in exudate, sputum or biopsy specimens, isolation in appropriate culture media and/or serology.
Treatment
Amphotericin is the drug of choice; itraconazole is an alternative.
Key facts
Calderone R.A., editor. Candida and candidiasis. Washington, DC: ASM Press, 2002.
Kibber C.C., MacKenzie D.W.R., Odds F.C., editors. Principles and practice of clinical mycology. Chichester: Wiley, 1996.
Reichart P., Samaranayake L.P., Philipsen H.P. Pathology and clinical correlates in oral candidiasis and its variants: A review. Oral Diseases. 2000;6:85-91.
Samaranayake L.P., MacFarlane T.W., editors. Oral candidosis. London: Wright, 1990.
Samaranayake L.P., Cheung L.K., Samaranayake Y.H. Mycotic infections of the oral cavity. Dermatologic Therapy. 2002;15:252-270.
Samaranayake L.P., Leung W.K., Jin L.J. Oral mucosal infections. Periodontology 2000. 2009;49:39-59.
Review questions (answers on p. 353)
Please indicate which answers are true, and which are false.


